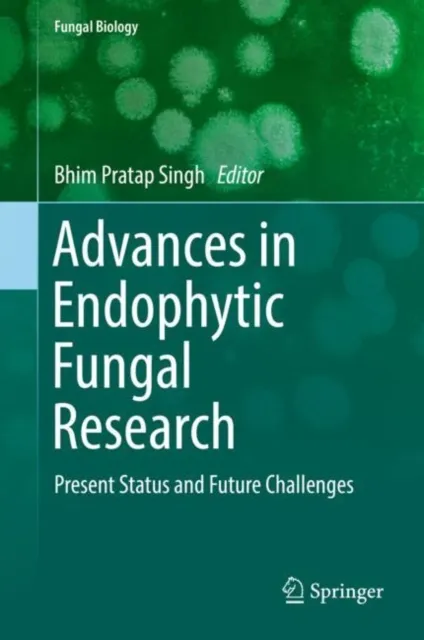
Advances in Endophytic Fungal Research

£199.50
Fungal Endophytes Volume I
Biodiversity and Bioactive Materials

Book Overview
This book explores the ecology and evolutionary dynamics of fungi. It focuses on identifying new metabolites extracted from endophytic fungi through genetic methods and bioassay-guided isolation. Detailed procedures for producing fungal endophyte metabolites for commercial use are also discussed. This book covers the diverse traits of fungal endophytes and their interactions with host plants, providing tactical insights into how these organisms can be utilized to their full potential in pharmaceutical, agricultural and industrial applications.
Intended Audience
This interdisciplinary reference is suitable for students and researchers in fields such as materials science, biology, plant science, microbiology, plant physiology and biotechnology. It is also useful for agri-food environmental scientists and agrochemical companies. In addition, the book offers valuable information for industrial scientists working on the synthesis and application of fungal secondary metabolites in plant science.